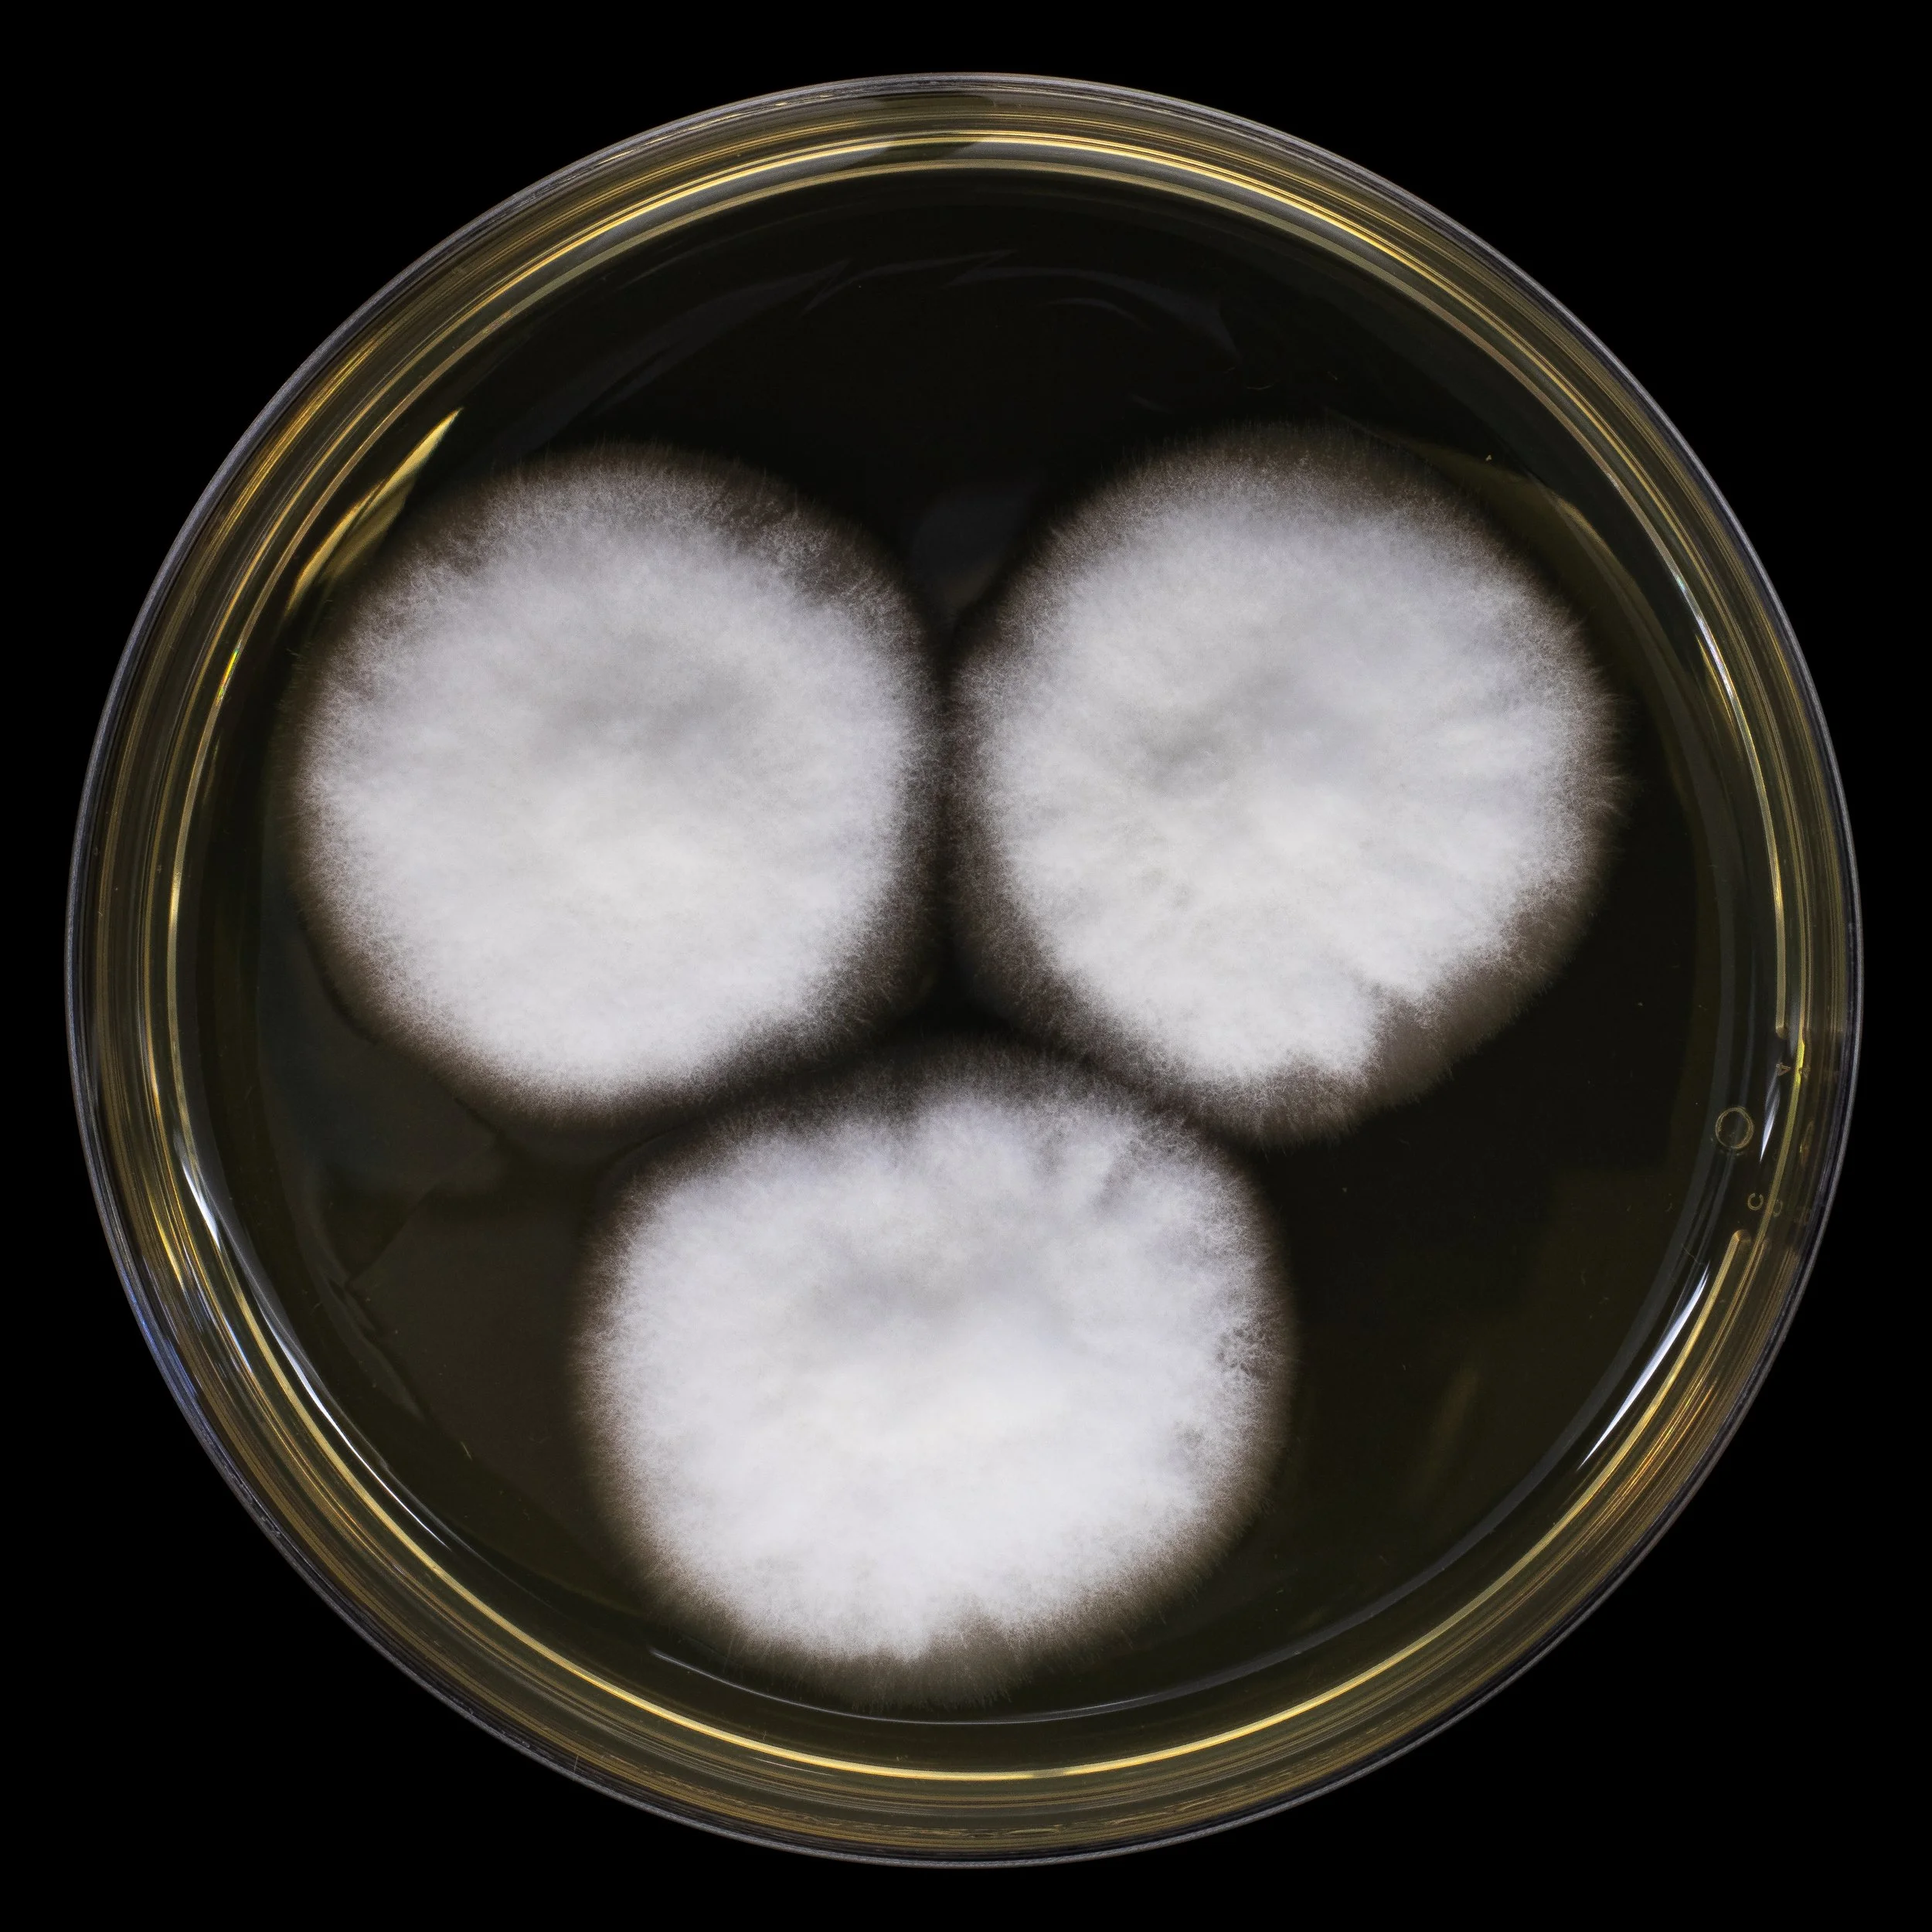

Our Technology
Green and Sustainable Production
Chitofun production is Green and Sustainable and it is based on utilizing renewable substrates and complete recycling of unused side-streams. It fulfills the European REACH regulation REACH Regulation - European Commission (europa.eu). The production process is controlled using advanced photonics sensors that allow precise production of high-quality fungal biomass. Chitofun process technology was developed at the Norwegian University of Life Sciences.

Next Generation Natural Fungal Chitosans
Fungal biomass produced by Chitofun is highly enriched with natural chitosan which is produced by fungal cells during fermentation process.

